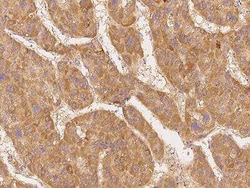
CDC2L1 Antibody, Novus Biologicals:Antibodies:Primary Antibodies

missing translation for 'onlineSavingsMsg'
Learn More
Learn More
CDC2L1 Antibody, Novus Biologicals™
Rabbit Polyclonal Antibody
€ 220.00 - € 326.00
Specifications
| Antigen | CDC2L1 |
|---|---|
| Dilution | Immunohistochemistry-Paraffin 1:200-1:1000 |
| Applications | Immunohistochemistry (Paraffin) |
| Classification | Polyclonal |
| Conjugate | Unconjugated |
| Product Code | Brand | Quantity | Price | Quantity & Availability | |||||
|---|---|---|---|---|---|---|---|---|---|
| Product Code | Brand | Quantity | Price | Quantity & Availability | |||||
|
18648408
|
Novus Biologicals
NBP3-06170-100ul |
100 μg |
€ 326.00
100µL |
Please sign in to purchase this item. Need a web account? Register with us today! | |||||
|
18643007
|
Novus Biologicals
NBP3-06170-50ul |
50 μg |
€ 220.00
50µL |
Please sign in to purchase this item. Need a web account? Register with us today! | |||||
Description
CDC2L1 Polyclonal antibody specifically detects CDC2L1 in Human samples. It is validated for Immunohistochemistry (Paraffin)Specifications
| CDC2L1 | |
| Immunohistochemistry (Paraffin) | |
| Unconjugated | |
| Rabbit | |
| Apoptosis, Cell Cycle and Replication, Cellular Markers, Protein Phosphatase, Signal Transduction | |
| PBS, pH7.0 | |
| 984 | |
| IgG | |
| Antigen and protein A Affinity-purified |
| Immunohistochemistry-Paraffin 1:200-1:1000 | |
| Polyclonal | |
| Purified | |
| RUO | |
| Human | |
| CDC2L1p58 CLK-1, CDC-related protein kinase p58, CDK11-p110, CDK11-p46, CDK11-p58, CDK11PITSLRE serine/threonine-protein kinase CDC2L1, cell division cycle 2-like 1 (PITSLRE proteins), Cell division cycle 2-like protein kinase 1, Cell division protein kinase 11B, cell division protein kinase 11B-like, CLK-1, cyclin-dependent kinase 11B, EC 2.7.11, EC 2.7.11.22, FLJ59152, Galactosyltransferase-associated protein kinase p58/GTA, p58, p58CDC2L1, p58CLK-1, PITSLREA, PK58 | |
| Produced in rabbits immunized with a synthetic peptide corresponding to the center region of the Human CDC2L1. | |
| Primary | |
| Store at 4°C short term. Aliquot and store at -20°C long term. Avoid freeze-thaw cycles. |
Spot an opportunity for improvement?Share a Content Correction
Product Content Correction
Your input is important to us. Please complete this form to provide feedback related to the content on this product.
Product Title